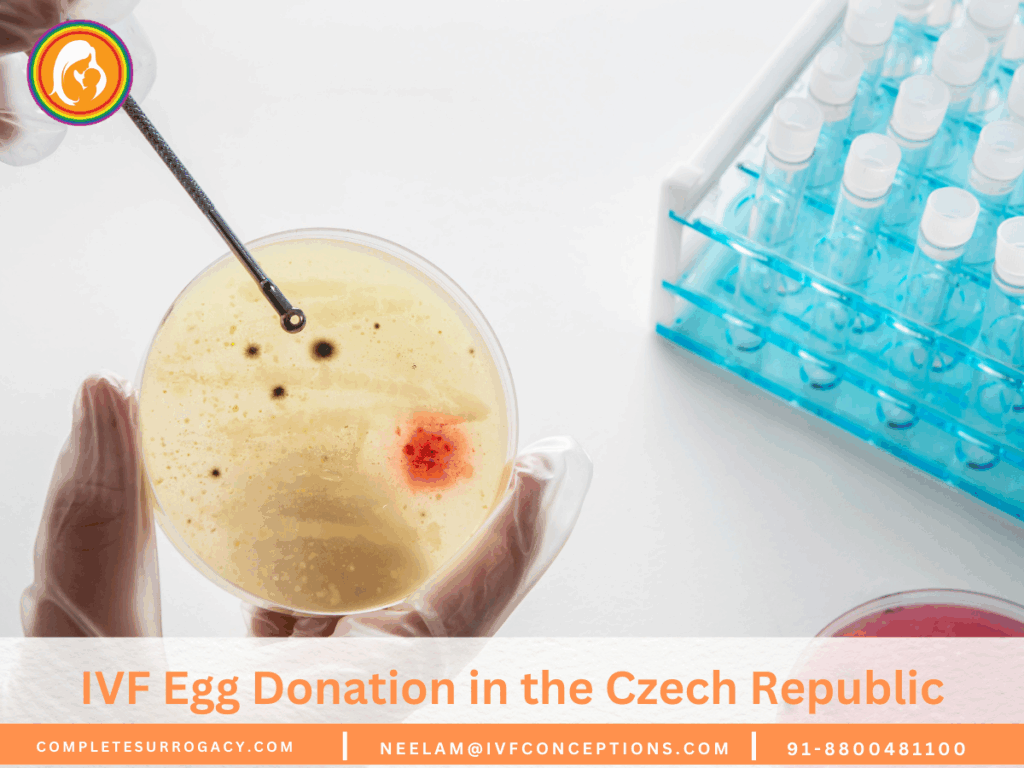
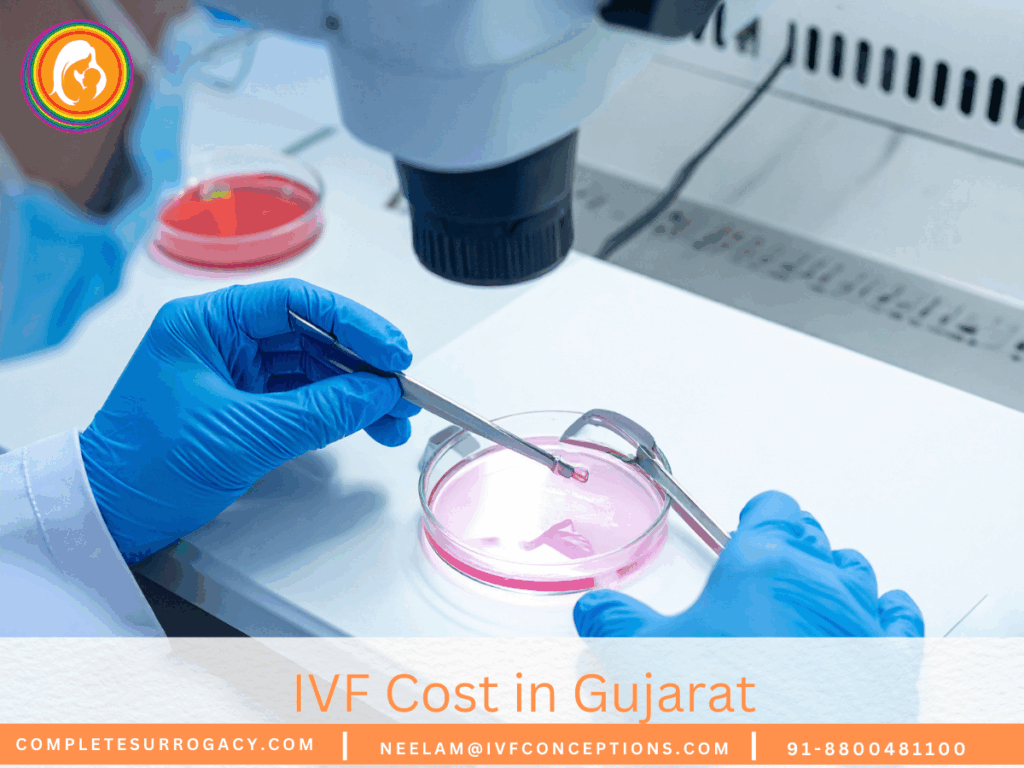
IVF Cost in Gujarat

Top IVF Clinics Worldwide for Fertility Treatment

Top IVF Clinics Worldwide for Fertility Treatment include globally recognized centers that combine cutting-edge reproductive technology, high success rates, and comprehensive patient support services. Leading clinics in destinations such as the United States, Spain, Greece, India, Mexico, and Georgia offer advanced IVF, ICSI, donor programs, genetic testing (PGT), and personalized care tailored to diverse fertility […]
IVF Egg Donation in the Czech Republic: Your Path to Parenthood
Ever thought about where caring fertility care meets top medical skills? The IVF with egg donation in the Czech Republic is one of the best options in terms of success rate and affordability of the fertility treatments. In the Czech Republic, fertility care is a mix of advanced tech, affordable prices, and top reproductive health […]
IVF Cost in Gujarat: What You Need to Know
Gujarat, one of India’s most progressive and medically advanced states, has become a popular destination for affordable IVF treatments. With a wide network of reputed fertility clinics in cities like Ahmedabad, Vadodara, Surat, and Rajkot, couples can access world-class IVF care at budget-friendly prices, often with high success rates and shorter waiting times. In this […]
